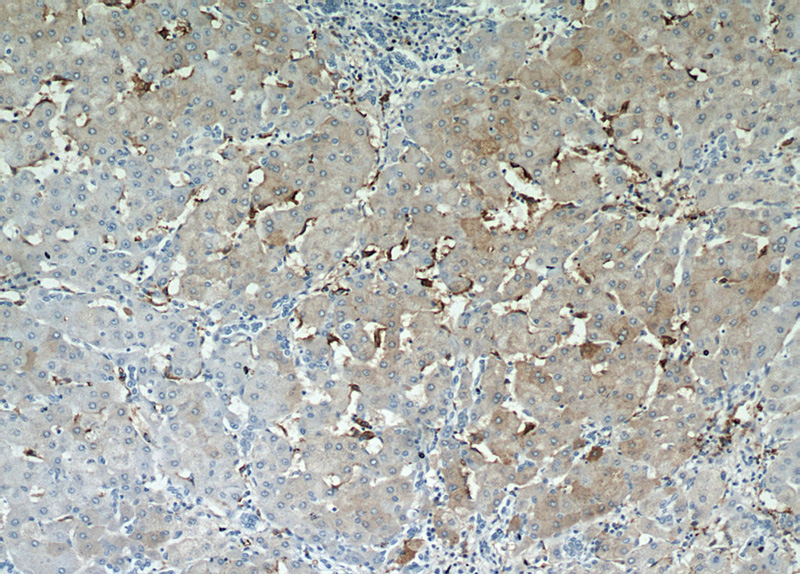
Immunohistochemical of paraffin-embedded human hepatocirrhosis using Catalog No:110429(F4-80 antibody) at dilution of 1:50 (under 10x lens)
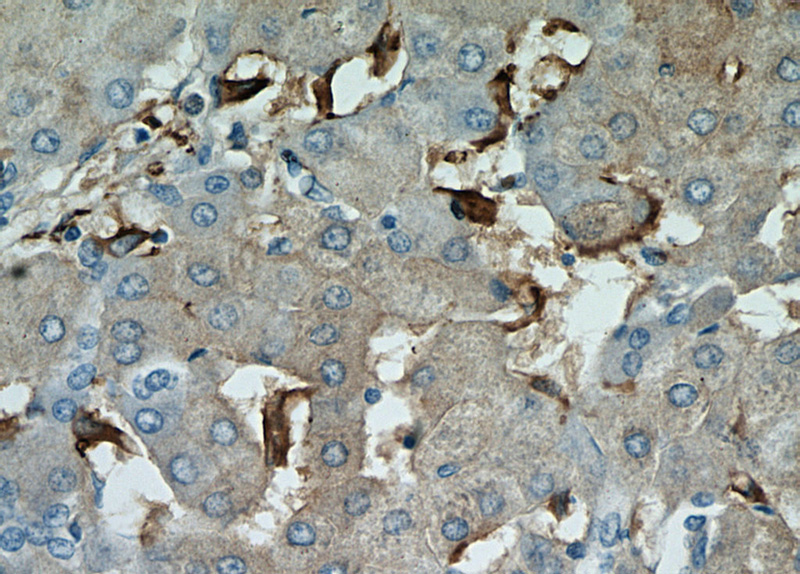
Immunohistochemical of paraffin-embedded human hepatocirrhosis using Catalog No:110429(F4-80 antibody) at dilution of 1:50 (under 40x lens)

-
Product Name
F4/80 antibody
- Documents
-
Description
F4/80 Rabbit Polyclonal antibody. Positive IHC detected in mouse spleen tissue, human hepat℃irrhosis tissue. Positive WB detected in Jurkat cells, HepG2 cells, L02 cells. Observed molecular weight by Western-blot: 130-140 kDa
-
Tested applications
ELISA, WB, IHC
-
Species reactivity
Human, Mouse; other species not tested.
-
Alternative names
DD7A5 7 antibody; EGF TM7 antibody; Emr1 antibody; F4 80 antibody; F4/80 antibody; Gpf480 antibody; Ly71 antibody; TM7LN3 antibody
-
Isotype
Rabbit IgG
-
Preparation
This antibody was obtained by immunization of Peptide (Accession Number: NM_010130). Purification method: Antigen affinity purified.
-
Clonality
Polyclonal
-
Formulation
PBS with 0.02% sodium azide and 50% glycerol pH 7.3.
-
Storage instructions
Store at -20℃. DO NOT ALIQUOT
-
Applications
Recommended Dilution:
WB: 1:200-1:2000
IHC: 1:50-1:500
-
Validations

Jurkat cells were subjected to SDS PAGE followed by western blot with Catalog No:110429(F4-80 antibody) at dilution of 1:500

Immunohistochemistry of paraffin-embedded mouse spleen tissue slide using Catalog No:110429(F4/80 Antibody) at dilution of 1:200 (under 10x lens). heat mediated antigen retrieved with Tris-EDTA buffer(pH9).

Immunohistochemistry of paraffin-embedded mouse spleen tissue slide using Catalog No:110429(F4/80 Antibody) at dilution of 1:200 (under 40x lens). heat mediated antigen retrieved with Tris-EDTA buffer(pH9).
Immunohistochemical of paraffin-embedded human hepatocirrhosis using Catalog No:110429(F4-80 antibody) at dilution of 1:50 (under 10x lens)
Immunohistochemical of paraffin-embedded human hepatocirrhosis using Catalog No:110429(F4-80 antibody) at dilution of 1:50 (under 40x lens)
-
Background
Mouse F4/80, also named as EMR1 and Gpf480, is a 160kd cell surface glycoprotein which is a member of the EGF TM7 family. The F4/80 molecule is solely expressed on the surface of macrophages and serves as a marker for mature macrophage tissues, including Kupffer cells in liver, splenic red pulp macrophages, brain microglia, gut lamina propria and Langerhans cells in the skin. The function of F4/80 is unclear, but it is speculated to be involved in macrophage adhesion events, cell migration or as a G protein-coupled signaling component of macrophages.
-
References
- Lee J, French B, Morgan T, French SW. The liver is populated by a broad spectrum of markers for macrophages. In alcoholic hepatitis the macrophages are M1 and M2. Experimental and molecular pathology. 96(1):118-25. 2014.
- Ying Y, Kim J, Westphal SN, Long KE, Padanilam BJ. Targeted deletion of p53 in the proximal tubule prevents ischemic renal injury. Journal of the American Society of Nephrology : JASN. 25(12):2707-16. 2014.
- Lv ZM, Wang Q, Chen YH, Wang SH, Huang DQ. Resveratrol attenuates inflammation and oxidative stress in epididymal white adipose tissue: implications for its involvement in improving steroidogenesis in diet-induced obese mice. Molecular reproduction and development. 82(4):321-8. 2015.
- Xiao W, Ren M, Zhang C, Li S, An W. Amelioration of nonalcoholic fatty liver disease by hepatic stimulator substance via preservation of carnitine palmitoyl transferase-1 activity. American journal of physiology. Cell physiology. 309(4):C215-27. 2015.
- Jang HS, Padanilam BJ. Simultaneous deletion of Bax and Bak is required to prevent apoptosis and interstitial fibrosis in obstructive nephropathy. American journal of physiology. Renal physiology. 309(6):F540-50. 2015.
- Zhang LF, Lou JT, Lu MH. Suppression of miR-199a maturation by HuR is crucial for hypoxia-induced glycolytic switch in hepatocellular carcinoma. The EMBO journal. 34(21):2671-85. 2015.
Related Products / Services
Please note: All products are "FOR RESEARCH USE ONLY AND ARE NOT INTENDED FOR DIAGNOSTIC OR THERAPEUTIC USE"
